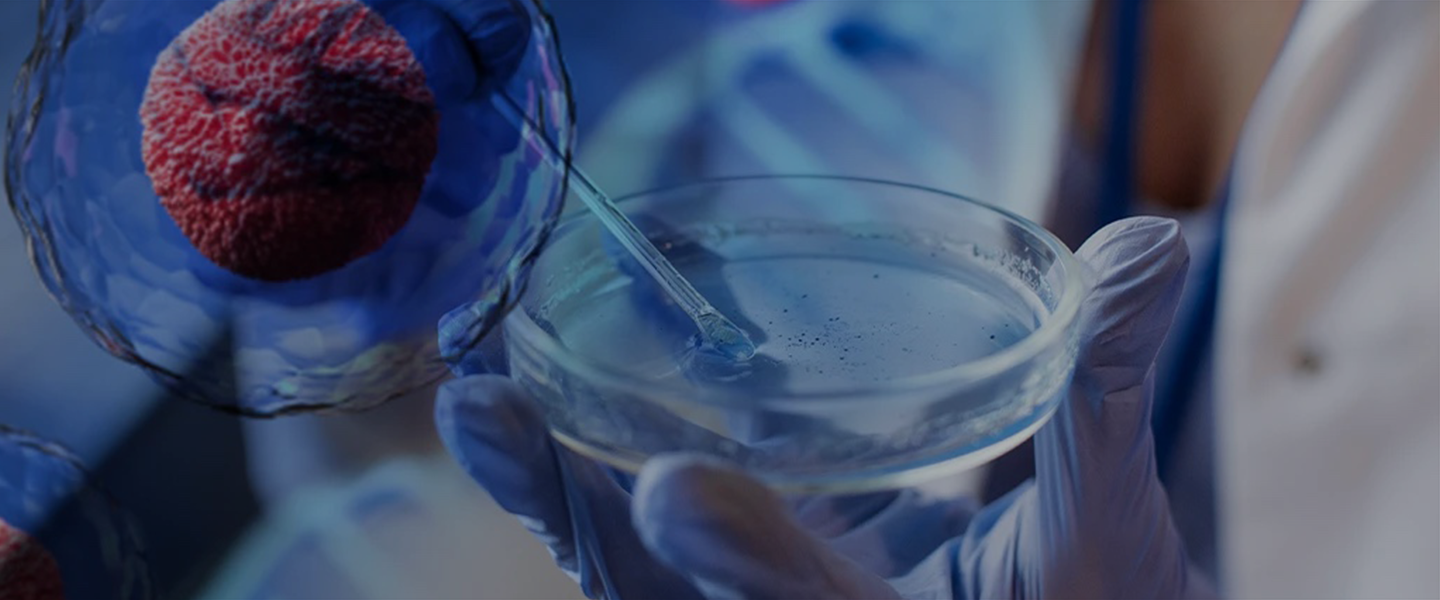
&nbsp;

Medicina Regenerativa del Dolor
La medicina regenerativa en Argentina representa una revolución en la forma de tratar afecciones degenerativas y lesiones deportivas. A través de terapias innovadoras como el Plasma Rico en Plaquetas (PRP), las células madre mesenquimales, el Concentrado de Médula Ósea (BMAC) y la microfragmentación de grasa (ADRCs), se busca reparar tejidos dañados, regenerar el cartílago y mejorar la calidad de vida de los pacientes.
El objetivo es claro: ofrecer alternativas no quirúrgicas, seguras y efectivas que permitan recuperar la movilidad, reducir el dolor y devolver bienestar en cada etapa de la vida.
Tratamientos y Tecnologías
En el campo de la traumatología y la medicina deportiva, la medicina regenerativa abre nuevas posibilidades:
Reservá tu turno y descubrí cómo mejorar tu calidad de vida
Enfoque y Compromiso
La medicina regenerativa en Argentina se desarrolla con un enfoque de Medicina 3.0, que promueve un cuidado proactivo y preventivo de la salud.
Empresas pioneras como Stem Cell Therapy Argentina y TMR Buenos Aires lideran este camino, acercando terapias avanzadas a más personas a través de innovación, ciencia y un modelo de atención seguro.
La seguridad y la ética son pilares fundamentales: todos los tratamientos se realizan en entornos controlados, siguiendo altos estándares médicos.
Los resultados comprobados respaldan la efectividad de estas terapias, que se presentan como una verdadera alternativa para pacientes con artrosis, dolor crónico o lesiones deportivas.
Reservá tu turno y descubrí cómo mejorar tu calidad de vida